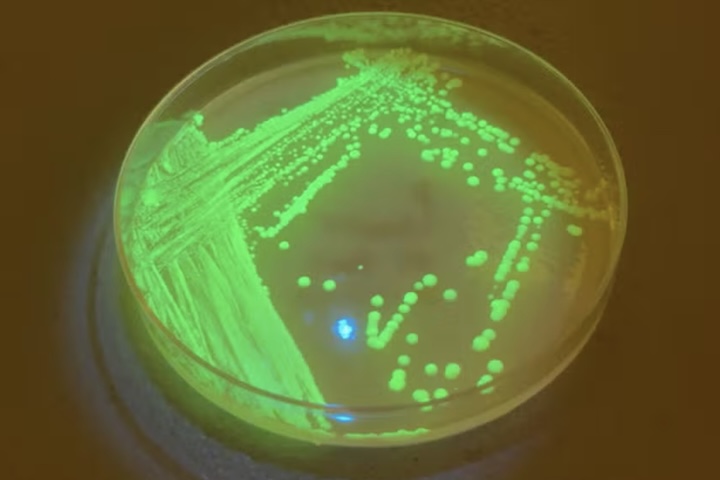
Para continuar com os experimentos, o pesquisador criou uma ONG chamada Gusteau Research Corporation.

Pesquisador desenvolve ‘cerveja vacinal’ e gera polêmica no meio científico

Os cookies nos ajudam a administrar este site. Ao usar nosso site, você concorda com nosso uso de cookies. Política de privacidade
Aceitar